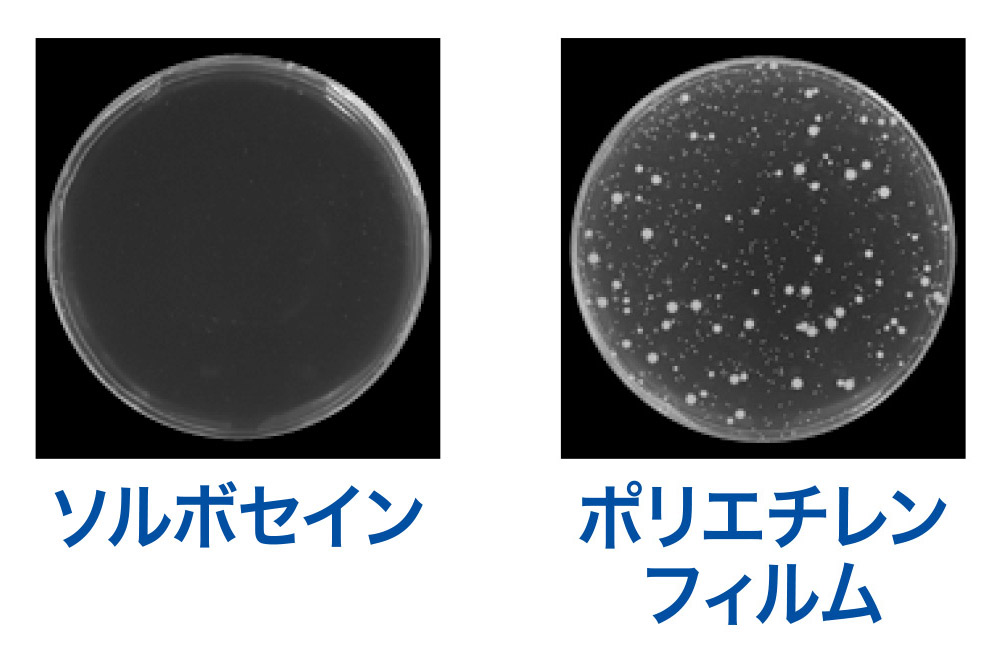

ソルボ外反母趾サポーター
外反母趾・内反小趾お悩みの対策は

①開いてしまった足指の付け根の部分を適切に締める
②重なりやすくなった指をパッドで適切な位置に収める
③曲がってしまい当たると痛い親指の付け根や
マメやタコが出来て痛い足裏をパッドで保護する

外反母趾サポーター選び方は?
親指が曲がり、足の付け根や足底のタコやマメが痛いです

使うシーンに合わせてしっかり優しく保護するサポーターを選びましょう
外反母趾サポーターは
ソルボセイン®使用のパッドでしっかり優しく保護できる
開いてしまった足の横アーチを適切に締められる
靴の種類や素足など様々なシーン毎にサポーターを装着する
これらを基準に選びましょう
どんなタイプで?
しめつけはどれくらい?
どんな時に使いたい?etc
お悩みやニーズに合ったサポーターがきっと見つかります!
外出にも
おうちケア
弱い
強い
しめつけ
拡大できます
- 足指間
パッドなし - 外反母趾
- 外反母趾
内反小趾 - 面
ファスナー
で固定 - かかと
固定
あり
初めての外反母趾サポーター
おすすめランキング
初めての方におすすめの人気ロングセラー商品 スーパーメッシュは足ムレ防止、薄型はほどよい締付け感、固定薄型はマジックテープで調整可能
極薄メッシュ生地でムレにくい ソルボ外反母趾サポーター スーパーメッシュ薄型
初めての方はまずはこれ! ソルボ外反母趾サポーター 薄型
ソルボ外反母趾サポーター 固定薄型メッシュタイプ
初めての外反母趾サポーター
左右セットおすすめランキング
初めての方におすすめの人気ロングセラー商品 左足用+右足用のセット商品 お得で便利にご購入
お得な左足用右足用のセット ソルボ外反母趾サポータースーパーメッシュ薄型左右セット
お得な左足用右足用のセット ソルボ外反母趾サポーター薄型左右セット
お得な左足用右足用のセット ソルボ外反母趾サポーター固定薄型メッシュタイプ左右セット
ご使用になったお客様から頂戴したレビュー
ソルボ外反母趾サポーター スーパーメッシュ薄型
レビューご評価 ★★★★★非公開希望
右外反母趾が悪化、変形と痛みが酷く整形外科へ。手術と1ヶ月の入院が必要とのこと、目の前が真っ暗に、そんな時、
知人に勧められソルボを着用、痛みが和らぐ。整形外科ではこれで落ち着いているなら急いで手術する必要はないとの診断、
明るい気持ちが戻ってきました。毎日ソルボに感謝です。。
ソルボ外反母趾サポーター 薄型
レビューご評価 ★★★★★50代女性
初めて購入しました。通販なので品質等心配でしたが、右のかなり進行している外反母趾を優しく包んでくれているようで、
通勤時にもとても安心感があります。届いた翌日から早速愛用しています。洗い替えにもう1つ購入予定です。良い商品をありがとうございます。
ソルボ外反母趾サポーター 固定薄型メッシュタイプ
レビューご評価 ★★★★★非公開希望
足外反母趾に対応するテープやサポーターもあれこれ買ったが、きつい、はめづらいなどで継続できなかった。
しかしこちらは装着しやすいのときつさを調節でき、靴も履けるとのことで使用を継続できている。
外反母趾は進行するので高齢者でも楽に装着できるところがとても良いと思う。
初めての外反母趾サポーター比較表
初めての外反母趾サポーター比較表
| 商品 | ![]() ソルボ外反母趾サポーター スーパーメッシュ薄型 |
![]() ソルボ外反母趾サポーター 薄型 |
![]() ソルボ外反母趾サポーター 固定薄型メッシュ |
|---|---|---|---|
| レビュー |
★★★★☆
4.50 (4) |
★★★★☆
4.33 (9) |
★★★★☆
4.00 (8) |
| 特徴 | 通気性抜群 足ムレ防止 | 適度な締め付け | メッシュ生地 締め付け調整可能 |
| 色 | ■ベージュ | ■ベージュ | ■シルバーグレー |
| サイズ | 左右別売り S(21.5~23.0cm) M(23.5~25.0cm) L(25.5~27.0cm) 2L(27.5~29.0cm) |
左右別売り S(21.5~23.0cm) M(23.5~25.0cm) L(25.5~27.0cm) |
左右別売り S(21.5~23.0cm) M(23.5~25.0cm) L(25.5~27.0cm) |
| 固定方法 固定力 固定場所 かかと固定 |
伸縮性生地 一定:やや弱い 中足骨関節 無し |
伸縮性生地 一定:標準 中足骨関節 無し |
伸縮性生地と マジックテープ 可変:標準~強い 中足骨関節 無し |
| ソルボセイン® パッド位置 |
親指 親指付け根 足裏 |
親指 親指付け根 足裏 |
親指 親指付け根 足裏 |
| 生地 縫製 |
ネットメッシュ 通常縫製 |
伸縮性ニット 通常縫製 |
パワーメッシュ 通常縫製 |
| 税込価格 | 2,420円 | 2,090円 | 2,530円 |
つま先にゆとりのある靴で
外反母趾サポーター
おすすめランキング
履くタイプの薄手生地サポーター つま先にゆとりのある靴が履けます ソルボ足指間パッドは指に沿った形なので優しくフィット
シームレス生地で目立ちにくい ソルボ外反母趾サポーター スキニーフィット
極薄メッシュ生地でムレにくい ソルボ外反母趾サポーター スーパーメッシュ薄型
スキニーフィットの締め付けで不足の方 ソルボ外反母趾サポーター スキニーパワーフィット
初めての方はまずはこれ! ソルボ外反母趾サポーター 薄型
つま先にゆとりのある靴で
外反母趾サポーター
左右セットおすすめランキング
履くタイプの薄手生地サポーター
左足用+右足用のセット商品 お得で便利にご購入
お得な左足用右足用のセット ソルボ外反母趾サポータースキニーフィット左右セット
お得な左足用右足用のセット ソルボ外反母趾サポータースーパーメッシュ薄型左右セット
お得な左足用右足用のセット ソルボ外反母趾サポータースキニーパワーフィット左右セット
ご使用になったお客様から頂戴したレビュー
ソルボ外反母趾サポーター スキニーフィット
レビューご評価 ★★★★★60代女性
外反母趾のサポーターは色々種類がありましたが、選択のポイントは薄くて蒸れない事、外出時に靴下の下に装着できる事、親指と隣の指が離れる事でした。
このサポーターは素材が程よく薄くてしっかりしています。装着すると少し締めつけ感はありますが、長時間つけたままでも違和感はありません。
親指と隣の指にはちょうどよい母感ができています。
ソルボ外反母趾サポーター スキニーパワーフィット
レビューご評価 ★★★★★非公開希望
初サポート力もよく、靴を履けるので便利。ただ、履くことがサポート力が強いため難しい。高齢の方、手の力が弱い方には不向きだと思う。
ソルボ外反母趾サポーター 薄型
レビューご評価 ★★★★★70代女性
外反母趾が痛く、親指が人差し指の上に載ってしまいバランスを崩してしまい転びそうになっていたのが,無くなりました
ありがとうございます
つま先にゆとりのある靴で外反母趾サポーター比較表
| 商品 |
![]() ソルボ外反母趾サポーター スキニーフィット |
![]() ソルボ外反母趾サポーター スーパーメッシュ薄型 |
![]() ソルボ外反母趾サポーター スキニーパワーフィット |
![]() ソルボ外反母趾サポーター 薄型 |
|---|---|---|---|---|
| 特徴 | 極薄生地使用 シームレス縫製 |
通気性抜群 足ムレ防止 | 極薄生地使用 シームレス縫製 当社製最大の締め付け |
適度な締め付け |
| 色 | ■ベージュ ■ブラウン |
■ベージュ | ■ベージュ ■ブラウン |
■ベージュ |
| サイズ | 左右別売り S(21.5~23.0cm) M(23.5~25.0cm) L(25.5~27.0cm) |
左右別売り S(21.5~23.0cm) M(23.5~25.0cm) L(25.5~27.0cm) 2L(27.5~29.0cm) |
左右別売り S(21.5~23.0cm) M(23.5~25.0cm) L(25.5~27.0cm) |
左右別売り S(21.5~23.0cm) M(23.5~25.0cm) L(25.5~27.0cm) |
| 固定方法 固定力 固定場所 かかと固定 |
伸縮性生地 一定:標準 中足骨関節 無し |
伸縮性生地 一定:やや弱い 中足骨関節 無し |
伸縮性生地 一定:一番強い 中足骨関節 無し |
伸縮性生地 一定:標準 中足骨関節 無し |
| ソルボセイン® パッド位置 |
親指 親指付け根 足裏 |
親指 親指付け根 足裏 |
親指 親指付け根 足裏 |
親指 親指付け根 足裏 |
| 生地 縫製 |
極薄伸縮性ニット 0.4mm厚 シームレス縫製 |
ネットメッシュ 通常縫製 |
極薄伸縮性ニット 0.4mm厚 シームレス縫製 |
伸縮性ニット 通常縫製 |
| 税込価格 | 2,420円 | 2,200円 | 2,640円 | 2,090円 |
つま先にゆとりのない靴で
外反母趾サポーター
おすすめランキング
着圧ストッキングやソックス生地で足指を整えます 指の付け根はゴム編で保護、足裏はソルボパッドで保護 つま先にゆとりの無い靴も履けます
※ソルボ足指間パッドはありません
外反が気になり始めたら ソルボバランスウォーク オープントゥガード
さらにアーチをしっかりサポート ソルボバランスウォークアーチサポート
2つの関節を締めて足指を開かせる ソルボ外反母趾・内反小趾トゥガード
つま先にゆとりのない靴で
外反母趾サポーター
3足セットおすすめランキング
つま先にゆとりの無い靴も履けます
左足用+右足用が組になっている商品の3個セットです
ご使用になったお客様から頂戴したレビュー
ソルボバランスウォークアーチサポート
レビューご評価 ★★★★☆50代女性
なるべく靴に響かない商品を探してこちらを購入
薄いので問題ないです
ソルボ外反母趾サポーター スキニーパワーフィット
レビューご評価 ★★★★☆50代女性
外反母趾対策、色々試しましたが、靴下タイプが使いやすいです。
以前は、指先が開いていて、先端が下がって、付け根が締まって痛かったのですが、このデザインだと問題無く、自然に親指が矯正された感があり、心地良い履き具合です!
つま先にゆとりのない靴で
外反母趾サポーター比較表
つま先にゆとりのない靴で
外反母趾サポーター比較表
| 商品 | ![]() ソルボバランスウォーク オープントゥガード |
![]() ソルボバランスウォーク アーチサポート |
![]() ソルボ外反母趾・内反小趾 トゥガード |
|---|---|---|---|
| 特徴 | ストッキング生地使用 | 着圧ストッキング生地使用 | 着圧ソックス生地使用 |
| 色 | ■ベージュ ■ブラック |
■ベージュ | ■ブラウン |
| サイズ | 1足(左右入り) フリーサイズ (22.0~25.0cm) |
1足(左右入り) フリーサイズ (22.0~25.0cm) |
左右別売り S(21.5~23.0cm) M(23.5~25.0cm) L(25.5~27.0cm) |
| 固定方法 固定力 固定場所 かかと固定 |
伸縮性生地 一定:やや弱い 中足骨関節 無し |
伸縮性生地 一定:標準 中足骨関節 無し |
伸縮性生地 一定:標準 中足骨関節 リフラン関節 無し |
| ソルボセイン® パッド位置 |
足裏 |
足裏 |
足裏 |
| 生地 縫製 |
ストッキング生地 ストッキング編み |
着圧ストッキング生地 ストッキング編み |
着圧ソックス生地 ソックス編み |
| 税込価格 | 2,728円 | 2,948円 | 1,760円 |
マジックテープでサイズ調整
おうちで使う 外反母趾サポーター
おすすめランキング
おうちでのケアも大切!
しっかり固定しマジックテープで調整可能
指の間と親指の付け根から足裏まで保護
マジックテープでサイズ調整
おうちで使う 外反母趾サポーター
左右セットおすすめランキング
おうちでのケアも大切!
左足用+右足用のセット商品 お得で便利にご購入
お得な左足用右足用のセット ソルボ外反母趾・内反小趾パワーアーチサポーター固定型左右セット
お得な左足用右足用のセット ソルボ外反母趾サポーター固定薄型メッシュタイプ左右セット
ご使用になったお客様から頂戴したレビュー
ソルボ外反母趾内反小趾パワーアーチサポーター固定型
レビューご評価 ★★★★★60代女性
このお品物を開発された方がたに感謝申し上げます。
とても気持ち良く無理なく足元にぴたりと着けられております。
個人差はあるかと存じますけれどもわりと長時間快適に使わせていただくことが出来ておりますので家の中での日常生活の足元の快適さが増しました。
ソルボ外反母趾サポーター 固定薄型メッシュタイプ
レビューご評価 ★★★★★女性
口コミも良かったこちらをプレゼントしました。
サポート力もあって、だいぶ歩くのが楽になったと喜んでくれました。
マジックテープでサイズ調整
おうちで使う外反母趾サポーター比較表
マジックテープでサイズ調整
おうちで使う外反母趾サポーター比較表
| 商品 | ![]() ソルボ外反母趾・内反小趾 パワーアーチサポーター固定型 |
![]() ソルボ外反母趾サポーター 固定薄型メッシュ |
|---|---|---|
| 特徴 | パワーベルトでしっかり固定 マジックテープで調整 |
メッシュ生地 締め付け調整可能 |
| 色 | ■ブラック | ■シルバーグレー |
| サイズ | 左右別売り S(21.5~23.0cm) M(23.5~25.0cm) L(25.5~27.0cm) |
左右別売り S(21.5~23.0cm) M(23.5~25.0cm) L(25.5~27.0cm) |
| 固定方法 固定力 固定場所 かかと固定 |
マジックテープと 伸縮性生地 可変:標準~強い 中足骨関節 リフラン関節 ヒールストラップ |
伸縮性生地と マジックテープ 可変:標準~強い 中足骨関節 無し |
| ソルボセイン® パッド位置 |
親指と小指 親指付け根 足裏 |
親指 親指付け根 足裏 |
| 生地 縫製 |
パワーメッシュ 通常縫製 |
パワーメッシュ 通常縫製 |
| 税込価格 | 4,950円 | 2,530円 |
外反母趾サポーター
内反小趾サポーター 兼用
おすすめランキング
外反母趾と内反小趾に対応
両指の間と親指の付け根から足裏まで保護
固定力を自在に調整 ソルボ外反母趾・内反小趾 固定薄型メッシュタイプ
ソルボ外反母趾内反小趾パワーアーチサポーター固定型
初めての方はまずはこれ! ソルボ外反母趾・内反小趾サポーター 薄型
外反母趾サポーター
内反小趾サポーター 兼用
左右セットおすすめランキング
外反母趾と内反小趾に対応
左足用+右足用のセット商品 お得で便利にご購入
お得な左足用右足用のセット ソルボ外反母趾・内反小趾サポーター固定薄型メッシュタイプ左右セット
お得な左足用右足用のセット ソルボ外反母趾・内反小趾パワーアーチサポーター固定型左右セット
お得な左足用右足用のセット ソルボ外反母趾・内反小趾サポーター薄型左右セット
ご使用になったお客様から頂戴したレビュー
ソルボ外反母趾・内反小趾 固定薄型メッシュタイプ
レビューご評価 ★★★★★40代女性
左足が内反小趾で、そこまで日常生活に支障はないのですが、このままだと悪化しそうなので購入しました。
装着するとラクで、この上に靴下を履いてスニーカーも履けます。
ソルボ外反母趾内反小趾パワーアーチサポーター固定型
レビューご評価 ★★★★★非公開希望
サポーターを装着すると足裏にしっかり力が伝わり、とても歩きやすくなった!と本人感激しております。
今まで立っているのも不安定だったのが、しっかりとした立ち姿になったことを目の当たりにし、プレゼントしてよかったと思っています。
ソルボ外反母趾・内反小趾サポーター 薄型
レビューご評価 ★★★★★60代女性
左足の第一趾がひどい外反母趾です。その為左足の第二趾が圧迫されて痛みが出るようになり、
内反小趾もあり、購入しました。
左第二趾の痛みがとれて、歩き易くなりました。
購入して、大正解でした
外反母趾・内反小趾サポーター比較表
外反母趾・内反小趾サポーター比較表
| 商品 | ![]() ソルボ外反母趾・内反小趾 固定薄型メッシュ |
![]() ソルボ外反母趾・内反小趾 パワーアーチサポーター固定型 |
![]() ソルボ外反母趾・内反小趾 サポーター 薄型 |
|---|---|---|---|
| 特徴 | 人気商品 初めてに最適 マジックテープで調整可能 |
パワーベルトでしっかり固定 マジックテープで調整 |
適度な締め付け |
| 色 | ■シルバーグレー | ■ブラック | ■ベージュ |
| サイズ | 左右別売り S(21.5~23.0cm) M(23.5~25.0cm) L(25.5~27.0cm) |
左右別売り S(21.5~23.0cm) M(23.5~25.0cm) L(25.5~27.0cm) |
左右別売り S(21.5~23.0cm) M(23.5~25.0cm) L(25.5~27.0cm) |
| 固定方法 固定力 固定場所 かかと固定 |
マジックテープと 伸縮性生地 可変:標準~強い 中足骨関節 無し |
マジックテープと 伸縮性生地 可変:標準~強い 中足骨関節 リフラン関節 ヒールストラップ |
伸縮性生地 一定:標準 中足骨関節 無し |
| ソルボセイン® パッド位置 |
親指と小指 親指付け根 足裏 |
親指と小指 親指付け根 足裏 |
親指と小指 親指付け根 足裏 |
| 生地 縫製 |
パワーメッシュ 通常縫製 |
パワーメッシュ 通常縫製 |
サテンニット 通常縫製 |
| 税込価格 | 2,750円 | 4,950円 | 2,530円 |
外反母趾予防サポーター
おすすめランキング
もしかして外反母趾かな?と思ったら 足の横ア
ーチが広がる前に対策をしましょう 薄手生地に面ファスナーで締め付けを調整できます
左足用と右足用の両方が組になっている商品です
いつもの靴が履ける薄型 ソルボフットサポーター ブラック
いつもの靴が履ける薄型 ソルボフットサポーター ベージュ
足裏のアーチをサポート ソルボヨコアーチフィット
外反母趾予防サポーター比較表
外反母趾予防サポーター比較表
| 商品 | ![]() ソルボ フットサポーター ブラック |
![]() ソルボ フットサポーター ベージュ |
![]() ソルボヨコアーチ フィット |
|---|---|---|---|
| 特徴 | 初めてに最適人気商品 サイズ調整可能 薄手生地 |
初めてに最適人気商品 サイズ調整可能 薄手生地 |
外反母趾予防 サイズ調整可能 薄い生地使用 |
| 色 | ■ブラック | ■ベージュ | ■ベージュ |
| サイズ | 左右別各1個の1足分 2S(19.5~20.5cm) S(21.0~22.5cm) M(23.0~24.5cm) L(25.0~26.5cm) 2L(27.0~28.5cm) |
左右別各1個の1足分 2S(19.5~20.5cm) S(21.0~22.5cm) M(23.0~24.5cm) L(25.0~26.5cm) 2L(27.0~28.5cm) |
左右別各1個の1足分 S(21.5~23.5cm) M(24.0~26.0cm) L(26.5~28.5cm) |
| ソルボセイン® パッド位置 |
新型ヨコアーチ (土踏まず前部) |
新型ヨコアーチ (土踏まず前部) |
ヨコアーチ (土踏まず前部) |
| 生地 縫製 |
ナイロン・ポリウレタン 通常縫製 |
ナイロン・ポリウレタン 通常縫製 |
ポリウレタン・ナイロン 通常縫製 |
| 税込価格 | 4,180円 | 4,180円 | 3,300円 |
外反母趾予防インソール
おすすめランキング
もしかして外反母趾かな?と思ったら 足の横ア
ーチが広がる前に対策をしましょう DSISソルボインソールは足のアーチをサポートします
左足用と右足用が組になっている商品です
★New★ DSISソルボレディース フルインソールタイプ
★テレビで紹介されました★パンプスのトラブルを和らげる DSISソルボレディース ハーフインソールタイプ
DSISソルボウォーキングエア WOMEN’S
DSISソルボランニングエア WOMEN’S
DSISソルボトレッキングエア WOMEN’S
外反母趾予防
インソール 比較表
外反母趾予防
インソール 比較表
| 商品 |
![]() DSISソルボレディース インソール |
![]() DSISソルボレディース ハーフインソール |
![]() DSISソルボウォーキングエア WOMEN’Sインソール |
![]() DSISソルボランニングエア WOMEN’Sインソール |
![]() DSISソルボトレッキングエア WOMEN’Sインソール |
|---|---|---|---|---|---|
| 特徴 | DSISインソール搭載 横アーチをサポート かかとと土踏まずを保護 衝撃吸収力と重さの 最適バランス 合成皮革使用 |
DSISハーフインソール搭載 横アーチをサポート かかとと土踏まずを保護 衝撃吸収力と重さの 最適バランス 合成皮革使用 |
DSISインソール搭載 横アーチをサポート かかとと土踏まずを保護 衝撃吸収力と重さの 最適バランス クッション性ある生地 ウォーキングシューズに |
DSISインソール搭載 横アーチをサポート かかとと土踏まずを保護 衝撃吸収力と重さの 最適バランス 足裏に密着しやすい生地 ランニングシューズに |
DSISインソール搭載 横アーチをサポート かかとと土踏まずを保護 衝撃吸収力と重さの 最適バランス かかとのぶれを抑制 トレッキングシューズに |
| お勧めの方 | パンプスを履く方 横アーチをサポート つま先からかかとまで保護 つま先にゆとりのあるパンプス |
パンプスを履く方 横アーチをサポート 土踏まずからかかとまで保護 つま先にゆとりの無いパンプス |
ウォーキングシューズを履く方 横アーチをサポート 土踏まずからかかとまで保護 つま先の蒸れを防止 |
パンプスを履く方 横アーチをサポート 土踏まずからかかとまで保護 つま先の蒸れを防止 |
パンプスを履く方 横アーチをサポート 土踏まずからかかとまで保護 つま先の蒸れを防止 |
| 生地/色 | ■ブラック
■アイボリー 合成皮革 |
■ブラック
■アイボリー 合成皮革 |
■グレー ヌバック調人工皮革 |
■赤 吸水速乾性カノコ生地 |
■グレー 吸水速乾性カノコ生地 |
| 形状 | ![]() 平らな形状 足の3つのアーチをサポート |
![]() 平らな形状ハーフインソール 足の3つのアーチをサポート |
![]() かかと若干高く包み込む形状 足の3つのアーチをサポート |
![]() かかと若干高く包み込む形状 足の3つのアーチをサポート |
![]() かかと若干高く包み込む形状 足の3つのアーチをサポート |
| ソルボセイン 使用箇所 青色部分 |
![]() DSISソルボインソール 足の横アーチサポート 全面微発泡ソルボ 重さ30g片足 |
![]() DSISソルボインソール 足の横アーチサポート 全面微発泡ソルボ 重さ23g片足 |
![]() DSISソルボインソール 足の横アーチサポート 全面圧縮不織布 重さ47g片足 |
![]() DSISソルボインソール 足の横アーチサポート 全面圧縮不織布 重さ37g片足 |
![]() DSISソルボインソール 足の横アーチサポート 全面圧縮不織布 重さ43g片足 |
| サイズ |
2S(22.0~22.5cm) S(23.0~23.5cm) M(24.0~24.5cm) L(25.0~25.5cm) |
2S(22.0~22.5cm) S(23.0~23.5cm) M(24.0~24.5cm) |
2S(22.0~23.0cm) S(23.5~24.5cm) M(25.0~26.0cm) |
2S(22.0~23.0cm) S(23.5~24.5cm) M(25.0~26.0cm) |
2S(22.0~23.0cm) S(23.5~24.5cm) M(25.0~26.0cm) |
| 幅(ワイズ) | 標準幅 | - | 標準幅 | 標準幅 | 標準幅 |
| 税込価格 | 2,420円(1ペア左右組) | 1,650円(1ペア左右組) | 2,530円(1ペア左右組) | 2,750円(1ペア左右組) | 3,300円(1ペア左右組) |
商品一覧
ソルボ外反母趾サポーター
こんなお悩みありませんか?
- 指の痛み
- 指の曲がり
- 足裏の痛み
(タコ・ウオノメ)
外反母趾とは
足の親指の付け根から人差し指の方向に曲がってしまう変形のことで、特に女性に目立つ症状です。

外反母趾のメカニズム
- アーチがゆるむ
- 指が内側に曲がる
- 足裏にタコ・ウオノメができる


ソルボ外反母趾サポーターを装着すると
- アーチを補整
- 指を開かせる
- タコ・ウオノメを保護する
ソルボ外反母趾サポーター

一般的なサポーター

一般的なサポーターは、足指間や母趾突起部分と足裏にパッドがなく、指が開きづらかったり、突起部分やタコ・ウオノメなどの部分をカバーしきれません。
また、足指間にシリコンのような素材のパッドがあるサポーターもありますが、食い込みによる痛みが出たり、すぐにへたってしまう場合もあります。
当社のソルボ外反母趾サポーターは、アーチを補整し指を開かせるサポーター機能に加え、ソルボ足指間パッドが親指と人差し指の間を広げ、ソルボ中足パッドが親指の付け根から足の裏側までしっかり覆います。
指が曲がることによる靴に当たる部分の痛みを緩和し、足裏をタコ・ウオノメから保護します。
ソルボセインとは
IPNs(相互貫入高分子網目構造)を持つ粘弾性高分子化合物で、皮膚や筋肉に類似の分子構造を持っています。その性質から人工筋肉と呼ばれています。

ソルボセインの3つの特徴
- 唯一無二の衝撃吸収・体圧分散性能
- へたったり食い込んだりしない
- 抗菌衛生性能
-
唯一無二の衝撃吸収・体圧分散性能
皮膚や筋肉と類似の分子構造を持つので同様の衝撃吸収・体圧分散をします。だから長時間装着しても違和感なく、しっかりサポートができます。

-
へたったり食い込んだりしない
素材自体の分子構造により衝撃吸収・体圧分散を実現しています。一般的な発泡素材のようなフォーム素材とは違い長期間使用してもへたったりしません。また、シリコンのように食い込んだりしません。

-
抗菌衛生性能
ソルボセインは抗菌性に優れ、バクテリア等の菌の増殖を抑える衛生的な素材です。
(一般財団法人カケンテストセンター調べ 抗菌性試験JIS Z2801に基づく)
サポーターの選び方・
サイズの合わせ方
サポーターの選び方
当社の商品は、仕様や強度、シーンに合わせてお選びいただける充実のラインナップとなっております。
シーン-
- ・初めての方におすすめ
- ・おうちで使う
- ・おでかけで使う
- ・外反母趾・内反小趾
仕様-
- ・面ファスナーで留めるタイプ
- ・ソックスのように履くタイプ
強度-
- ・足あたりがやさしいタイプ
- ・しっかり締めるパワータイプ
サイズの合わせ方
靴のサイズを参考にしてください。
サイズ選びに不安のある方は、上の写真のように足囲を計測してみてください。
測定値が靴のサイズより大きい場合は、1サイズ大きめをお勧めします。
当ストアでは、1回に限りサイズ交換ができます。
装着時のご注意・お手入れ方法
装着時のご注意
足指間パッドを指の間にズレないように挟み込み、足裏の中足パッドを適切な位置に来るように装着してください。
初めて装着する場合は1~2時間ぐらいの短い時間から始め、様子を見ながら徐々に時間を延ばしてください。
(※就寝時は外してください)
洗濯時のご注意
お洗濯は手洗いでお願いしております。
中性洗剤を用いて、ぬるま湯で押し洗いをしていただき、タオルなどで水気をふき取り陰干ししてください。
ソルボセインは衝撃を吸収し長期間ご使用いただけますが、折り曲げに弱い性質があります。
洗濯機のご使用やもみ洗いは避けてください。
ソルボセインがあると
何が良いの?
ソルボセインのポイント
ソルボセインは、皮膚や筋肉に近い分子構造を持つため、人体と同じ衝撃吸収性能があります。体に優しくしっかり長時間サポートできるのが特徴です。
親指と人差し指の間の「ソルボ足指間パッド」が、指の重なりや指の曲がりを軽減します。「ソルボ中足パッド」が親指の付け根から足裏までしっかり覆うので、指の曲がりによって靴に当たる痛みの緩和や、足裏をタコ・ウオノメから保護します。
選ばれる3つの理由
-
-
POINT 1
衝撃吸収素材のパイオニアです!
ソルボセインは、英国国立研究開発公社(NRDC)の支援で誕生した衝撃吸収素材です。
衝撃吸収と圧力分散性能を実現する人工筋肉として医療の現場で高く評価されており、さらにゴムやEVAなどに比べて違和感やへたりがはるかに少なく、耐久性にも優れています。
当ストアは、そのソルボセインを開発・製造している三進興産株式会社が運営する公式オンラインストアです。
-
-
POINT 2
のべ470万人の方にご愛用されています!
当社の外反母趾サポーターシリーズは、1993年の発売開始以来、32年間でのべ470万人の外反母趾でお悩みの方に外反母趾対策でご愛用いただいております。
-
-
POINT 3
プライム市場上場企業の全額出資会社です!
当ストアを運営している三進興産株式会社は、東京証券取引所プライム市場上場のアキレス株式会社の全額出資会社です。
お客様のお悩みに寄り添うべく、さまざまな仕様の商品をラインアップし、日々、開発・製造・販売を行っております。
また、足の専門資格(フットコントロールトレーナー)を取得している社員が16名在籍し、確かな信頼と実績をお届けいたします。
ソルボ≪公式≫オンラインストアは多くの種類の
外反母趾サポーターを取りそろえています。
足の専門資格を持つ社員16名がサポーター選びをお手伝いします。
FCTスキルアップ研修会参加者集合写真
足の専門資格を持つ社員が16名在籍し、確かな信頼と実績をお届けいたします。
外反母趾のお悩みには、痛い、タコ・ウオノメ・マメ、などさまざまです。
私たちは足の横アーチに着目して外反母趾研究家(柔道整復師 笠原巌先生)と共に商品を開発してきました。
サポーター選びがご不安な場合は、お問い合わせいただけましたらおすすめの外反母趾サポーター探しをお手伝いいたします。
ソルボ≪公式≫オンラインストアは、お客様のお悩みに寄り添い、お客様のご満足に役立てるよう、これからも尽力してまいります。
外反母趾 対策
- 早期に自覚が外反母趾対策(治す)の基本
- 外反母趾とは?
- 足指の筋力アップに 外反母趾対策 足指じゃんけん
- 外反母趾を進行させないための 外反母趾対策 簡単トレーニング
- 足のアーチを鍛える 外反母趾対策 つま先立ち体操
- アーチの崩れを予防 外反母趾対策 タオル寄せ運動(タオルギャザー)
- 足指の筋力アップに 外反母趾対策 足指じゃんけん
- 外反母趾サポーター おすすめ
- 強剛母趾とは?
- 強剛母趾にも外反母趾サポーターをご使用いただけます
- 外反母趾サポーター おすすめ人気ランキング
早期に自覚が外反母趾対策(治す)の基本
早期に自覚することが、外反母趾対策(治す)の基本です。
母趾の変形・痛みを感じたら早めに整形外科を受診しましょう。
治療には保存療法(手術をしない治療法)と手術療法が有るようです。
保存療法には、運動療法と装具療法が有るようです。
運動療法は、つま先立ち体操、タオル寄せ運動、足指じゃんけん等があります。
装具療法は、足底挿板、テーピング等があります。
テーピングは専門的な技術が必要になり、ご自身で行うことに難しさを感じられる方も多いようです。
ソルボ外反母趾サポーターは手軽にテーピングと同じ様な状態を実現します。
また、ソルボDSISインソールは足底挿板に使用されることが多いです。
外反母趾とは?
外反母趾とは足の親指が付け根から人差し指の方向に曲がってしまう変形のことで、特に女性に目立つ症状です。
1,親指の付け根の内側が腫れる
2,足指が外側に曲がり始める
3,骨が曲がったり、出っ張る
4,2次的な障害を併発
外反母趾と気づいても「ただ親指が曲がるだけ」と、軽く考えないでください。外反母趾は2次的障害を発生させるところに大きな問題があるのです。
自分で出来る外反母趾チェック
足の外周を鉛筆でなぞり、足形を取ります。親指の最も出っ張ったところと親指の先を結ぶラインに定規を当て、線を引く。
かかとから親指の最も出っ張ったところを結ぶラインに定規を当て、線を引く。
この角度が15度以上なら外反母趾の可能性が高い。
外反母趾を進行させないための 外反母趾対策(治す) 簡単トレーニング
体を支える足の骨は左右で56個あり体全体の約1/4です。 足の骨に沿って筋肉が分布しており、関節を安定させることで姿勢を保ち、正常な動きをすることができます。 外反母趾を改善・予防するには、普段から足のトレーニングを継続して行うことが有効です。つま先立ち体操、タオル寄せ運動、足指じゃんけんがあります。 簡単トレーニングは医師の指示に従い実施してください。足の状態のよっては適切では無い場合があります。
足のアーチを鍛える 外反母趾対策 つま先立ち体操
かかとを浮かせてつま先に体重をかけるつま先立ちは、足のアーチのくずれを防ぐのに有効です。はだしになって床にまっすぐ立ち、
イスなどの背もたれを持ってつま先立ちをします。これを20回を1セットとして毎日3セット行いましょう。
アーチの崩れを予防 外反母趾対策 タオル寄せ運動(タオルギャザー)
イスに座って床にタオルやネクタイ、スカーフなどを置きます。
左右どちらか一方の足の5本の足指を全部使ってこれらをたぐり寄せ、足指でつかんで持ち上げます。
それぞれ片足で15秒持ち上げたらもう一方の足でも同様に行います。これを2〜3回くりかえしてください。
足指の筋力アップに 外反母趾対策 足指じゃんけん
はだしになって床に足を前に投げ出して座ります。左右それぞれの足指でじゃんけんをします。
5本の足指に力を入れ、ギュッと曲げるのがグー、親指だけを上に上げるのがチョキ、全ての足指を全て広げるのがパーです。
それぞれの足指を鍛える効果があります。
外反母趾サポーター おすすめ
当社の外反母趾サポーターシリーズは、1993年の発売開始以来、30年間で延べ430万人の外反母趾でお悩みの方にご愛用いただいております。
[初めて]、[おうちで使う]、[お出かけで使う]、[外反母趾内反小趾]など、様々なご利用シーンに合う豊富な商品があります。
ソルボセインは、皮膚や筋肉に近い分子構造を持つため、人体と同じ衝撃吸収性能があります。体に優しくしっかり長時間サポートできるのが特徴です。
強剛母趾とは?
強剛母趾は、母趾中足趾節関節(MTP関節)の軟骨がすり減ったり変形したりして骨と骨の隙間がなくなり痛みや腫れをおこします。
外反母趾や痛風などと間違われることが多いですが、母趾の付け根の関節の足の甲側に隆起が見られることが特徴です。
強剛母趾は、つま先を反らせて蹴り出す動作の時の痛みが特徴です。
強剛母趾の方も外反母趾サポーターをご使用いただけます
サポーターが足指の手前にある中足趾節関節をしっかり補強します。これにより母趾の反り返りが調整されます。
ソルボセインは、皮膚や筋肉に近い分子構造を持つため、人体と同じ衝撃吸収性能があります。体に優しくしっかり長時間サポートできるのが特徴です
外反母趾サポーター 内反小趾サポーター (強剛母趾サポーター) おすすめ 人気ランキング
初めてのサポーター
おすすめ人気ランキング第1位 ソルボ外反母趾サポータースーパーメッシュ薄型 2,200円(税込)
おすすめ人気ランキング第2位 ソルボ外反母趾サポーター薄型 2,090円(税込)
おすすめ人気ランキング第3位 ソルボ外反母趾サポーター固定薄型メッシュタイプ 2,530円(税込)
おうちで使うサポーター
おすすめ人気ランキング第1位 ソルボ外反母趾・内反小趾パワーメッシュ固定型 3,630円(税込)
おすすめ人気ランキング第2位 ソルボ外反母趾サポーター固定型 2,750円(税込)
おすすめ人気ランキング第3位 ソルボ外反母趾サポーター固定薄型メッシュタイプ2,530円(税込)
お出かけで使うサポーター
・つま先にゆとりの無い靴
おすすめ人気ランキング第1位 ソルボバランスウォークオープントゥガード2,728円(税込)
おすすめ人気ランキング第2位 ソルボバランスウォークアーチサポート2,948円(税込)
おすすめ人気ランキング第3位 ソルボ外反母趾・内反小趾トゥガード1,628円(税込)
・つま先にゆとりの有る靴
おすすめ人気ランキング第1位 ソルボ外反母趾サポータースキニーフィット2,420円(税込)
おすすめ人気ランキング第2位 ソルボ外反母趾サポータースキニーパワーフィット2,640円(税込)
おすすめ人気ランキング第3位 ソルボ外反母趾サポーター薄型2,090円(税込)
外反母趾・内反小趾サポーター
おすすめ人気ランキング第1位 ソルボ外反母趾・内反小趾固定薄型メッシュタイプ2,750円(税込)
おすすめ人気ランキング第2位 ソルボ外反母趾・内反小趾サポーター 薄型2,530円(税込)
おすすめ人気ランキング第3位 ソルボ外反母趾サポーター固定薄型メッシュタイプ3,630円(税込)









































ネットショッピングをされない方